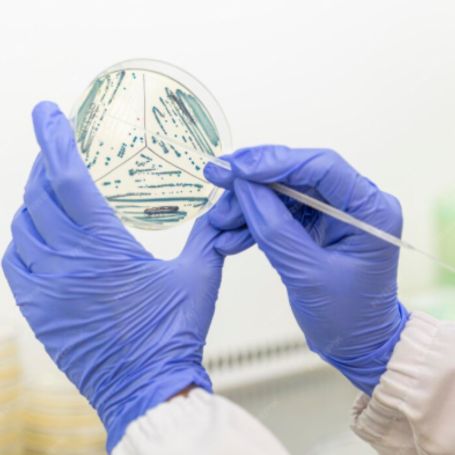

At Diagnopein Diagnostic Centre in Nashik, the HPE-Gall Bladder test is conducted by skilled pathologists using advanced laboratory techniques ensuring accurate and dependable


Histopathological Examination (HPE) of the gall bladder is a critical diagnostic test for analyzing gall bladder tissue after surgical removal (cholecystectomy). It involves microscopic evaluation to detect diseases such as inflammation, gallstones, polyps, and especially gall bladder cancer, which may go unnoticed by imaging tests. HPE confirms diagnoses and helps doctors understand the tissue changes at a cellular level.
Gall bladder diseases can be asymptomatic or mimic other illnesses, so precise tissue examination is necessary. The HPE test plays a significant role in:
Detecting hidden malignancies: Early-stage gall bladder cancer often remains undetected until HPE reveals malignant cells.
Confirming diagnosis: Differentiates between benign inflammation, gallstones, and malignant pathology.
Post-surgical assessment: Helps confirm if the diseased tissue was completely removed during surgery.
Guiding treatment: Pathology results help doctors decide if additional surgery or therapy is needed.
At Diagnopein Nashik, every gall bladder specimen is carefully examined with latest histology techniques, giving patients and doctors confidence in the diagnosis.
Undergoing the HPE-Gall Bladder test at Diagnopein offers multiple benefits:
Precise Diagnosis: Microscope-level examination provides definitive diagnosis of gall bladder disease.
Early Cancer Detection: Identifies carcinoma in early stages, improving treatment outcomes.
Comprehensive Analysis: Examines tissue features like inflammation, fibrosis, polyps, or cancer cells.
Peace of Mind: Helps patients understand their condition clearly through detailed pathology reports.
Expert Report Delivery: Fast, accurate, and thorough reports by experienced pathologists at Diagnopein Nashik.
These benefits help in timely and effective patient management, minimizing risks and improving prognosis.
The HPE-Gall Bladder test involves several procedural steps at Diagnopein Diagnostic Centre Nashik:
Specimen Collection: The gall bladder tissue removed during surgery is collected in a preservative solution (formalin).
Gross Examination: Pathologists visually inspect the tissue for abnormalities such as thickening or masses.
Tissue Processing: Selected sections of tissue are processed—dehydrated, embedded in paraffin wax, and sliced into microscopic thin sections.
Microscopic Staining: The thin tissue slices are stained using special dyes (Hematoxylin and Eosin) to highlight cellular features.
Detailed Microscopic Analysis: Pathologists examine the stained tissue under a microscope to identify inflammation, polyps, cancer cells, or other pathological changes.
Final Reporting: Results are documented with clinical correlation and shared with the referring doctor promptly.
Diagnopein Nashik uses NABL-accredited lab facilities equipped with modern histopathology instruments that ensure reliable testing and fast turnaround times.
The HPE-Gall Bladder test report from Diagnopein Nashik provides:
Gall bladder wall thickness and texture analysis
Identification of gallstones, cholesterolosis, or polyps
Presence and degree of inflammation (acute or chronic cholecystitis)
Dysplasia or malignancy features if present
Final conclusive diagnosis based on microscopic findings
Reports are crafted by certified pathologists with clinical notes facilitating accurate treatment recommendations. Diagnopein ensures all reports meet international quality standards.
Renowned diagnostic centre in Nashik with advanced technology
Experienced certified pathologists specialized in histopathology
Quick and accurate test results delivered digitally or at centre
Hygienic sample collection and laboratory practices aligned with NABL standards
Affordable pricing with transparent billing and no hidden costs
Convenient location and patient-friendly services at Nashik centre
With Diagnopein Nashik, patients and receive reliable, detailed, and timely HPE-Gall Bladder diagnostic services for optimal care.
If cancerous cells are detected, your doctor will recommend further diagnostic tests and treatments, which may include imaging studies, blood tests, and consultation with an oncologist. Early detection of gallbladder cancer through HPE can improve treatment outcomes.
No, the HPE Gallbladder Test itself is not painful because it is performed on the removed gallbladder tissue. The discomfort a patient may feel is related to the cholecystectomy (gallbladder removal surgery) rather than the histopathological examination.
Since the HPE test is performed on gallbladder tissue after surgery, there is no specific preparation needed for the test itself. You will, however, need to follow pre-surgical instructions from your surgeon before undergoing gallbladder removal.
The HPE test itself has no risks, as it involves examining tissue that has already been removed. Any risks associated are linked to the surgery itself, not the histopathological examination.